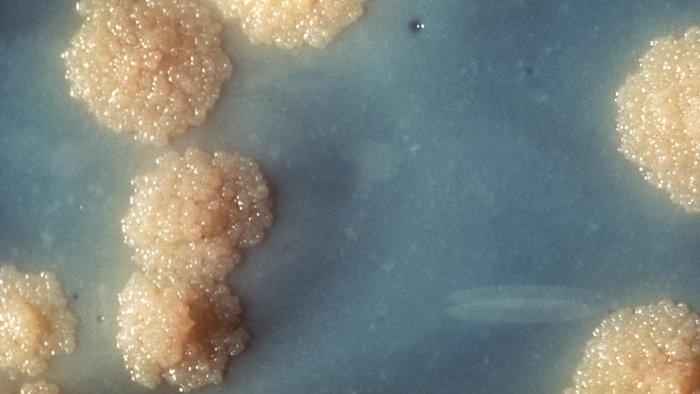
Instituto de Salud Carlos III (ISCIII) tweet media

Zaida Herrador retweetledi

La desigualdad 📈 la #tuberculosis
👉 reorientar los programas de control: faltan epidemiólogos, enfermeras de salud pública, agentes comunitarios y ⬆️ la prioridad política y presupuestaria que se da a la TB
gacetadesalud.com/actualidad-gs/… via @GacetadeSalud @sespas @seepidemiologia
Español